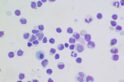

For Professor Jacques Miller, a fragment of conversation he overheard as a child sent him on a scientific quest that defined his professional life; a life that became an extraordinary one.
Scientific bafflement
Miller was only eight when he heard a doctor trying to explain to his mother how helpless the medicine of the day was against the tuberculosis that was consuming Miller’s eldest sister.
Miller remembers, “The doctor kept saying, ‘We don’t understand anything about resistance to infectious disease.’”
In 1940 there were no antibiotics for tuberculosis, and Jacques watched as his sister, a beautiful girl of 17, wasted away and died within three months.
Many years later, as a medical researcher, Miller pierced that scientific bafflement. He solved the key mysteries of how the human body fights infection, and how its defence systems sometimes go into destructive overdrive.
“He is the living person who most deserves the Nobel Prize and never got it,” declares Sir Gustav Nossal, director of the Walter and Eliza Hall Institute for 31 years. “He was the person who discovered the function of the thymus [a small organ that sits above the heart behind the breastbone]. The thymus was seen as an evolutionary relic that did little or nothing – Jacques Miller discovered it was, in fact, the conductor of the immunological orchestra. It is the mastermind organ of the immune system.”
This, and another key discovery by Miller, have led to new treatments of illnesses ranging from autoimmune diseases such as lupus, immunodeficiency diseases such as Di George syndrome, and cancer.
A scientific quest begins
The French-born Miller arrived in Australia in 1941 at the age of 10 after years living in China, where his father worked for an international bank. His father had decided Australia would be the best place for the family as World War Two raged. Miller spoke almost no English at first: “I tried to make friends at school but I had to buy a book of Australian ‘Strine’ to understand what they were saying.”
He became a doctor partly because of his sister’s death and partly because he had hated the killing in World War II: “I didn’t want to be a soldier and have to kill people. I thought, ‘If I become a doctor, they won’t give me a gun. They’ll give me a syringe and I can work in a hospital.’”
Cracking the thymus mystery
Miller did his medical training in Sydney, but it was as a medical researcher in London in 1961 that he made his first big discovery. He was studying the blood cancer leukaemia in mice. At that stage the thymus was known only as a graveyard for dying white blood cells called lymphocytes. Miller discovered that the thymus actually makes lymphocytes (T cells) and sends them out into the rest of the body where they fight infections.
This was the key to many other important discoveries. A thymus that goes into a production frenzy and produces too many lymphocytes causes leukaemia. A thymus that produces T cells that don’t work properly and attack the body’s own cells, rather than bacteria or viruses, causes autoimmune diseases such as lupus.
And now it has been discovered that T cells can also be used to cure cancer, Miller says.
Cancer cells sometimes have antigens on their surface and a type of ‘tool’ that prevents T cells from attacking and killing them. The molecular structure of that ‘tool’ has recently been discovered in America, and if you block it, the T cells can attack the cancer cells. Many melanomas are curable now.
Cellular soldiers uncovered
Miller’s second major discovery was equally as triumphant. He was curious about why, even if he removed the thymus in newborn mice, they still could produce some antibodies. Where could the antibody-forming cells have come from, if not the thymus?
He found the answer in 1968, a year after he arrived at the Walter and Eliza Hall Institute: the bone marrow. A second kind of blood cell that forms antibodies is made in the bone marrow (B cells). B cells and T cells are tailored to defend the body against different infections; when your body is infected with a particular germ, only the B cell or T cell that recognises it will respond. Those selected cells then quickly multiply, forming an army of cellular soldiers to defeat the infection. Special types of T cells and B cells ‘remember’ the invader and help make you immune to further attacks.
Miller was awarded the Florey Medal and the highest honour other than a Nobel, the Royal Society’s Copley Medal. Previous winners of the Copley include Charles Darwin and Albert Einstein.
What did it feel like to make discoveries that have proved so important to science? His eyes light up and he takes a deep breath: “Absolutely spectacular.”